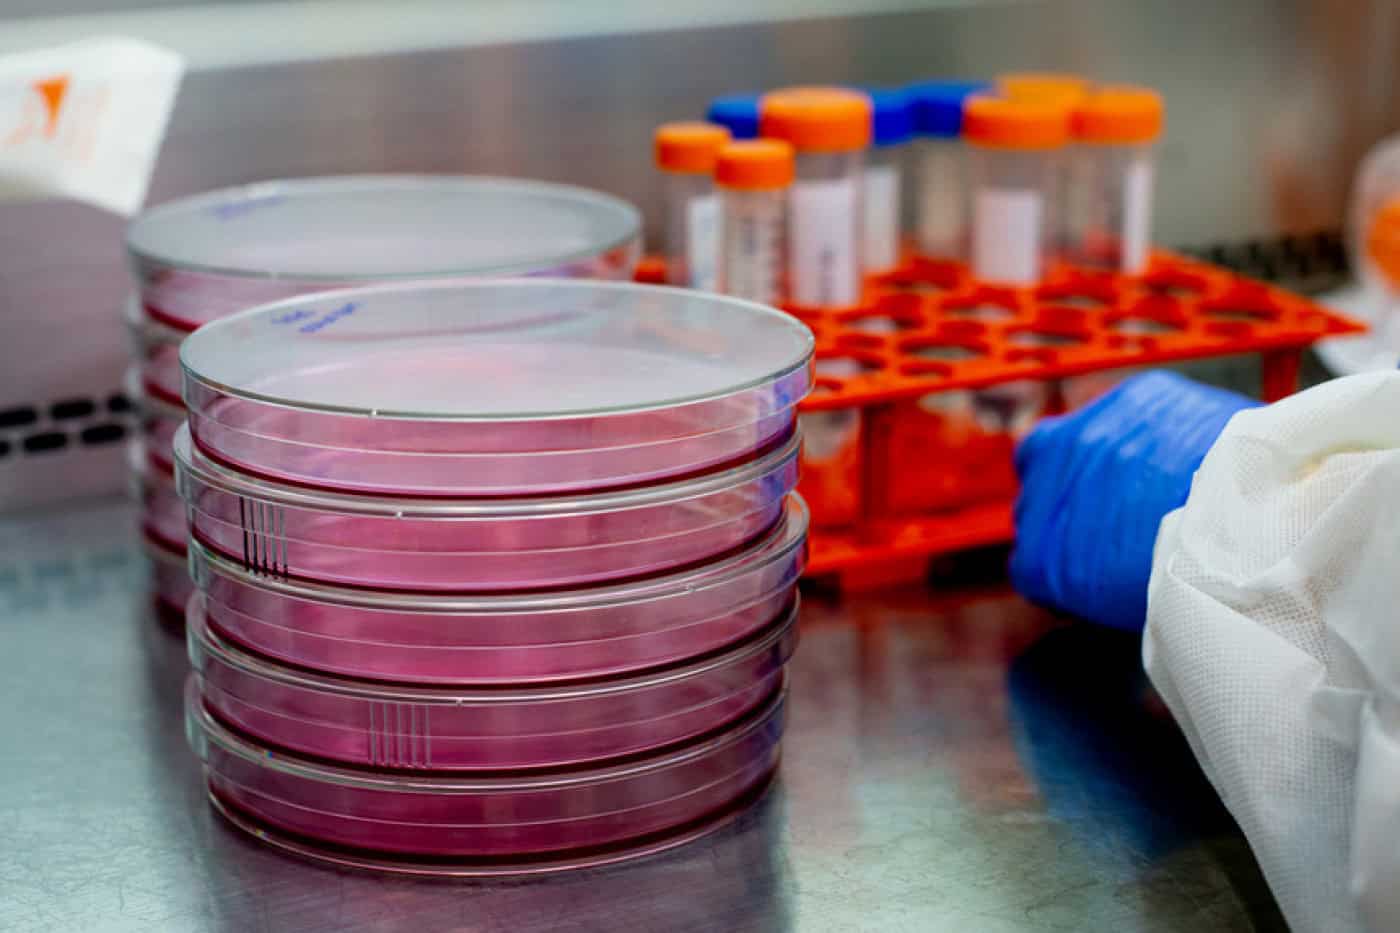
Milhares de docentes e investigadores fora do diploma que prolonga contratos

Milhares de docentes e investigadores fora do diploma que prolonga contratos
Milhares de professores e investigadores precários ficaram excluídos do diploma que pretendia prolongar o vínculo laboral e assegurar o trabalho desenvolvido nas instituições e laboratórios, alertou esta terça-feira o Sindicato Nacional de Ensino Superior (SNESup).
Na semana passada foi publicado um diploma que veio suspender os prazos de caducidade dos contratos de trabalho nas instituições de ciências, tecnologia e ensino superior e prolongá-los por mais 90 dias.
A luta pela prorrogação destes contratos não é de agora, mas só no final de julho foi aprovado no parlamento o projeto de lei publicado agora em Diário da República que reconhece esse direito.
No entanto, o presidente do SNESup, Gonçalo Leite Velho, explicou que o diploma só se aplica aos contratos atualmente em vigor:
“Os milhares de pessoas cujos contratos terminaram em julho já não estão abrangidos”, alertou em declarações à Lusa.
Segundo contas sindicais, no total há mais de dez mil docentes cujos contratos terminam entre julho e agosto assim como milhares de investigadores e bolseiros.
No caso dos docentes, o contrato terminou mas o trabalho não, já que a pandemia de covid-19 fez com os prazos habituais do ano letivo fossem atrasados, como aconteceu, por exemplo, com as datas dos exames.
Na mesma situação estão milhares de investigadores e bolseiros, cujo trabalho esteve temporariamente suspenso devido à pandemia que obrigou ao teletrabalho: “Houve trabalho de laboratório e académico que passou para setembro”, sublinhou Gonçalo Leite Velho.
O SNESup exige que a situação destes trabalhadores seja resolvida e critica as instituições que, reiteradamente, têm pedido mais trabalho por menos salário. “Não é justo que sejam os mais precários e frágeis a pagar a crise”, lamentou.
Lusa
